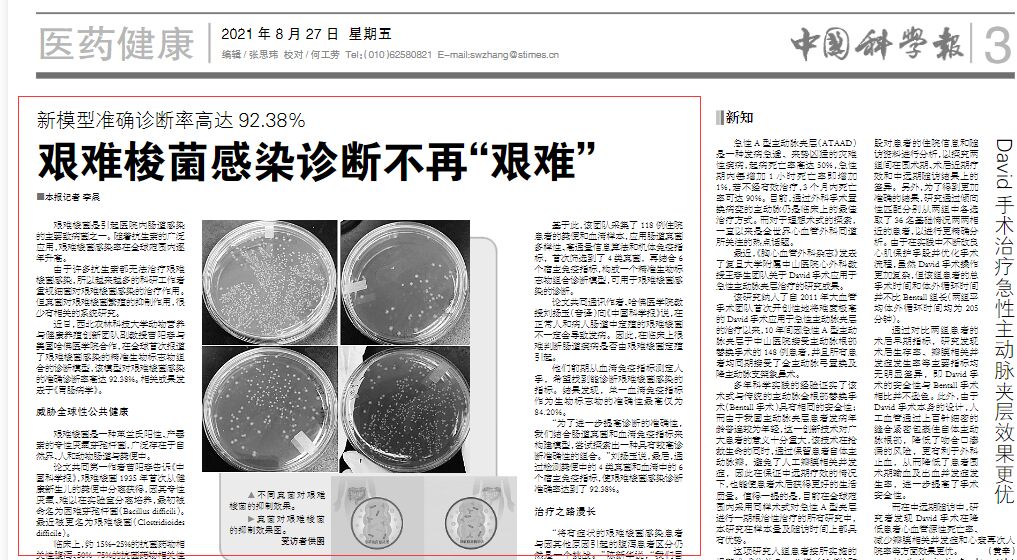
3e0231970f4a4e109dd7ce2ebd131fb0.jpg

8月27日,中国科学报对小黄书 动物营养与健康养殖创新团队曹阳春副教授进行了题为“艰难梭菌感染诊断不再’艰难’ ”的专访。对于曹阳春副教授发表在消化道权威杂志《Gastroenterology》(影响因子:22.682)题为“Fecal Mycobiota Combined with Host Immune Factors Distinguish Clostridioides difficile Infection from Asymptomatic Carriage”的论文进行了深入解读。
近年来,艰难梭菌感染已对全球公共健康造成威胁,被美国疾病控制与预防中心列入最高紧急威胁级别的耐药菌首位。曹阳春副教授与美国哈弗医小黄书 合作,在全球首次报道了艰难梭感染的精准生物标志物组合的诊断模型,该模型对艰难梭菌感染的准确诊断率高达92.38%。未来计划将从枝孢菌属和曲霉属真菌中开发具有预防和治疗艰难梭菌感染的益生真菌。